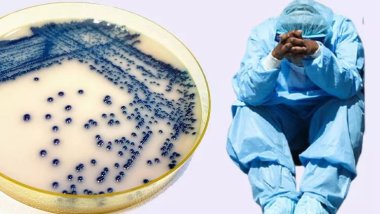
ABD'de 'ölümcül mantar' alarmı: Hastalar 90 gün içinde ölüyor

Nisan 25, 2026 0
Nisan 30, 2026 0
Mayıs 11, 2026 0
Mayıs 11, 2026 0
Mayıs 23, 2026 0
Mayıs 23, 2026 0
Mayıs 23, 2026 0
Mayıs 23, 2026 0
Mayıs 23, 2026 0
Mayıs 23, 2026 0
Mayıs 23, 2026 0
Mayıs 23, 2026 0
Mayıs 23, 2026 0
Mayıs 23, 2026 0
Mayıs 22, 2026 0
Mayıs 22, 2026 0
Mayıs 22, 2026 0